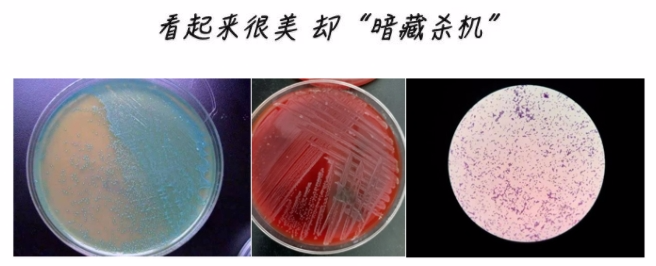

据说,这个世界有两种人:e人和i人。
对于e人来说,哪怕是在返工返学路上,他们也可以玩出花。

i人呢?不好意思!i人表示根本不出门。如果不是要打工,真的可以在家从大年初一躺到除夕。
不过,长期宅家,靠冰箱存货养活的本 i人,看到这个活生生的案例时真的瑟瑟发抖!

小静(化名)今年30岁,她每天下了班,哪都不想去,就喜欢回家躺着刷剧吃吃喝喝。

那天周末她跟往常一样宅在家,午餐就是冰箱里的隔夜披萨,因为懒得加热,所以直接拿出披萨就啃。
没想到这一口披萨,就让她摊上“大祸”。
3天后,她莫名其妙头痛、肌肉酸痛,一开始以为是感冒,吃了颗止痛药就去睡了。
但一觉起来,症状不但没好转,头痛炸裂,还开始呕吐,脖子也变得僵硬。
察觉到不对劲的她火速前往深圳市第二人民医院就诊,医生一听发病历程和症状后,隐隐不安——可能是脑膜炎。
果然,一番检查下来,脑室已经有感染的表现,能看得出脑脊液分层了。
腰穿出来的脑脊液,也都是浑浊的脓液,一般正常的脑脊液是清水状。

咋办?别无他法,脑膜炎发展为脑室炎了,只能做颅脑手术。
手术过程中,医生发现小静的脑室因为细菌繁殖,里面已经像个“盘丝洞”,到处结满了蜘蛛网,一定要清理干净再结合抗生素治疗。
但就好比在结满蜘蛛网和霉菌的墙皮上做大扫除,要做到一尘不染,又不伤墙皮一分一毫,难度不言而喻。
一旦不慎伤到脑室壁或血管,随时可能引发颅内大出血。医生用脑室镜探查脑室的第一视角整个脑室像“盘丝洞”所幸,后来手术过程顺利,小静也在医院继续接受药物治疗。话说回来,好好地,怎么吃了口隔夜披萨就摊上脑膜炎呢?
其实,是李斯特菌这个“冰箱杀手”在“搞鬼”。

李斯特菌,一种广泛存在于自然界中的菌株,对环境的适应能力很强。

在0~45摄氏度的温度下,无论是酸性还是碱性条件下,它都能大量繁殖,甚至在零下20摄氏度的冷冻环境中也能活得好好的,江湖人称“冷酷杀手”。
它是引起食源性疾病暴发的主要病原菌,也是致命的食源性病原体之一,其致死率可达20%~50%。
李斯特菌平板菌落特征及镜下特征
李斯特菌属于条件致病菌,可以通过被污染的食物,经过消化道、眼睛、破损的皮肤和黏膜进入人体造成感染,其引起的中毒多发生在夏秋季。

生奶源及其制品、冰激凌、生食的水果蔬菜、肉及肉制品、冷的熟食生食类、烟熏类海产等,都是容易被李斯特菌污染的食品。

对于健康的成年人来说,李斯特菌致病力有限。
万一真吃了受李斯特菌污染的食物,可能会出现腹泻、恶心、呕吐、发热、头痛、肌肉痛等症状。
但以下几类人群,就要打起十二分精神了!

孕妇、新生儿、老人及免疫功能低下者等,是李斯特菌的重点攻击对象。
国外监测数据显示,孕产妇病例约占李斯特菌病病例的1/3; 另有文献总结,孕妇李斯特菌的感染率是非孕人群的18倍左右。

孕妇感染后,李斯特菌可通过胎盘、产道感染胎儿,严重者会导致流产、死胎、早产、新生儿败血症等。
其他免疫力低下的人群,可能会引起败血症、脑膜炎等,严重可致命。

李斯特菌有个最大的“软肋”——怕热,巴氏灭菌、烧熟煮透这些简单的措施就能对付它。
我们可以通过以下措施来降低感染风险:
1.避免生食未经任何消毒处理的蔬菜和肉类,烹饪蛋类、肉类和海鲜时要保证熟透。
2.避免摄入未经巴氏消毒的奶和乳酪,以及用它们制作的食品。
3.吃水果前要充分清洗,最好去皮后再食用。买即食食物时,应检查食品包装密封是否完整。
4.使用冰箱要做到:生熟分开,分开区域,定期清理,定时清洁。

5.从冰箱里拿出来的生冷食物,应经过60~70摄氏度的温度持续加热15分钟再食用。
6.处理生熟食物的刀具、砧板和存放食物的用具要分开,不能混用。